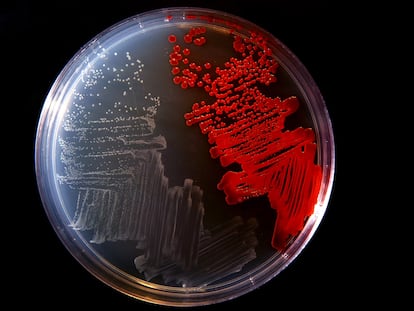

Virus terapéuticos contra ‘superbacterias’
Expertos en el uso de fagos contra microbios resistentes a antibióticos defienden esta forma de luchar contra las infecciones recurrentes

Expertos en el uso de fagos contra microbios resistentes a antibióticos defienden esta forma de luchar contra las infecciones recurrentes

Vaxdyn supera las fases preclínicas de su formulación contra las bacterias resistentes a los antibióticos y espera empezar los ensayos con humanos en dos años

El responsable del estudio de las bacterias de los chicles defiende las aplicaciones de su labor y encaja con elegancia el reconocimiento de los galardones que parodian a los de la Academia Sueca

Los científicos están recurriendo a los depredadores naturales de las bacterias para tratar las infecciones, en un problema que se ha convertido en unos de los grandes desafíos de la medicina moderna
Científicos del Reino Unido demuestran cómo reescribir el genoma de una bacteria para que produzca proteínas que no existen en la naturaleza y que sea genéticamente inmune a las infecciones

Los preparados dispensados en farmacias españolas ya facturan 121 millones tras crecer un 65% en cuatro años

El estudio de los trabajos del pintor italiano permite crear una huella biológica de las obras de arte

Causa cada año más muertes de menores de cinco años en el mundo que cualquier otra enfermedad: más de 800.000. En la mayoría de los casos se podrían haber evitado, puesto que resulta fácil detectarla, es prevenible y curable. Pero algo falla
Con un 19% de vidas infantiles perdidas por esta enfermedad prevenible y curable, es el país más afectado del mundo. Gobierno e iniciativas internacionales buscan reducir la cifra con un nuevo plan. La pandemia es un freno, pero también un acicate

Científicos españoles emprenden una investigación para hallar los mecanismos inmunológicos por los que la microbiota podría proteger al cuerpo del virus y reducir la gravedad de los síntomas
Un ensayo recientemente concluido ha conseguido disminuir el dengue en Indonesia un 77%. El equipo quiere expandir el proyecto a otros países y continentes

El médico y microbiólogo búlgaro investigó los beneficios para la salud del alimento tradicional de su país y también contribuyó a la consecución de la vacuna contra la tuberculosis

El nuevo medicamento, liderado por un científico español, logra que el 80% de los ratones en los que se probó sobreviva a una infección letal

Un grupo de investigadores obtiene la secuencia genética de la cepa original de Penicillium, un hallazgo que también puede ayudar a combatir las resistencias actuales

Hasta ahora, se han detectado señales indirectas que se han atribuido a actividad biológica fuera de la Tierra, pero siempre han estado lejos de ser pruebas irrefutables

Un análisis de restos europeos sugiere que la bacteria que provoca la enfermedad ya estaba presente en Europa a principios del siglo XV, pero reconoce que los viajes pudieron favorecer su expansión

Hay microbios funcionales en estratos suboceánicos de 100 millones de años

En la fabricación del popular antiséptico se usó un lote de un principio activo contaminado por la bacteria Serratia marcescens